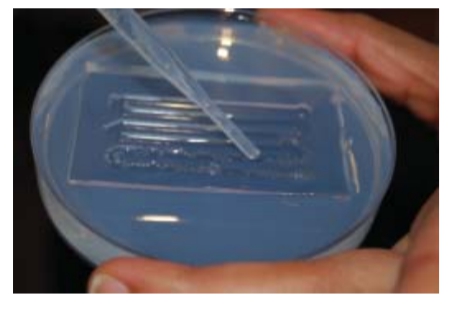

顯微注射與移植模具(Transplantation Molds)
顯微注射與移植模具(Transplantation Molds)
產品說明
處理斑馬魚胚胎的更簡單方法
產品:斑馬魚胚胎模具
型號:Z-MOLDS
- 用於高通量顯微注射研究
- 使胚胎排列以利於注射
- 可重覆使用
- 一套四種模組


使用方式:
1、將3%瓊脂溶解於水中,並加熱至溶液沸騰。
2、將融化的瓊脂小心倒入培養皿中。
3、用冷水清洗模具。
4、將模具有紋路的一面朝下放入溶解的瓊脂溶液中。
5、等瓊脂固化。(可放置4度加速固化)
6、一旦凝固則可彎折瓊脂板鬆開模具。然後,使用模具上面的把手輕輕將其從瓊脂中取出備用。



模具應用說明:
蛋白質組學與大量篩選
此款模具被設計用於許多胚胎的注射,最多可高達1000個。
在瓊脂凝膠上由模具製成的凹槽使得胚胎可自行對準。

異種移植與幼魚注射
此款模具設計用於幼魚的注射
傾斜隆起的部份在瓊脂凝膠形成完美的弧度,可以更容易對幼魚進行顯微注射

移植
此款模具被設計為了提高顯微注射的速度。
注射時只需簡單轉動培養皿即可。

標準顯微注射
此款模具是專門用於胚胎細胞的移植

1、將3%瓊脂溶解於水中,並加熱至溶液沸騰。
2、將融化的瓊脂小心倒入培養皿中。
3、用冷水清洗模具。
4、將模具有紋路的一面朝下放入溶解的瓊脂溶液中。
5、等瓊脂固化。(可放置4度加速固化)
6、一旦凝固則可彎折瓊脂板鬆開模具。然後,使用模具上面的把手輕輕將其從瓊脂中取出備用。

模具應用說明:
蛋白質組學與大量篩選
此款模具被設計用於許多胚胎的注射,最多可高達1000個。
在瓊脂凝膠上由模具製成的凹槽使得胚胎可自行對準。

異種移植與幼魚注射
此款模具設計用於幼魚的注射
傾斜隆起的部份在瓊脂凝膠形成完美的弧度,可以更容易對幼魚進行顯微注射

移植
此款模具被設計為了提高顯微注射的速度。
注射時只需簡單轉動培養皿即可。

標準顯微注射
此款模具是專門用於胚胎細胞的移植


